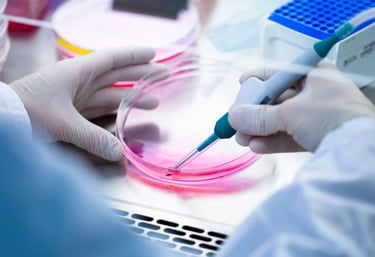

INTERNATIONAL INSTITUTE OF REGENERATIVE AESTHETICS
Master Regenerative Aesthetic Medicine
IIRA is the official medical society that is dedicated to the practice & advancement of Aesthetic Medicine.
We represent and welcome all physicians and dentists & healthcare professionals regardless of specialties.
The mission of the IIRA is to provide the highest quality education & aesthetic medical training.
We offer Certification and Fellowship training to physicians & certified training courses in aesthetic and regenerative medicine. Our experienced faculty members are experts in the art of aesthetic medicine. We provide aesthetic medicine training nationally & internationally.
Asia Aesthetic Courses and Training Center:
Pakistan, Malaysia, Maldives & Thailand
Middle East Aesthetic Courses and Training Centers:
Dubai/UAE, Abu Dhabi/UAE
Courses
Basic to advanced aesthetic medicine training
Hands-on learning with latest techniques
Certification to boost your credentials
Research
Support
Empowering Regenerative Medicine
At IIRA, we guide physicians through expert training in aesthetic and bio-regenerative medicine to enhance patient care with confidence.


150+
15
Trusted Worldwide
Certified Experts
Our Services
Empowering physicians with hands-on training in aesthetic and regenerative medicine.
Courses
From basics to advanced techniques in aesthetic medicine and bio-regeneration.


Certification
Official recognition to validate your expertise in regenerative aesthetics.
Standards that ensure quality and excellence in patient care.
Research

Get in Touch
Questions about courses or certifications? Reach out to our team anytime.
Phone
+1-800-555-0199
info@iira-edu.com
arsalan.khan@iira-edu.com